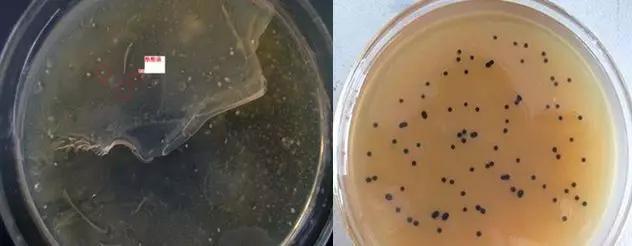
水产丁酸梭菌的正确用法,丁酸梭菌的用法用量

丁酸梭菌(Clostridium butyricum)又名酪酸菌,它是梭状芽孢菌属中的一个种,存在于土壤,人和动物粪便中,是一种专性厌氧的革兰氏阳性芽孢杆菌,两端钝圆,细菌呈直杆状或稍有弯曲,单个或成对,短链,偶见有丝状菌体,周身鞭毛,能运动。丁酸梭菌能产生丁酸、乳酸等,促进双歧杆菌、乳酸菌等肠道有益菌群增殖,抑制葡萄球菌、大肠杆菌、伤寒沙门氏菌、产膜梭菌等致病菌和腐败菌的生长,能促进肠道微生物平衡,降低胺类、吲哚、硫化氢等有害物质的产生。丁酸梭菌及其代谢产物能提高饲料利用率和改善畜禽肉质,增强畜禽免疫力和抗病力。

由于丁酸梭菌属于厌氧菌,在工业生产和菌落计数当中都采用厌氧培养的方式,然而丁酸梭菌在厌氧发酵过程中产生大量的气体,特别是在菌落计数中丁酸梭菌产生的气体常常会涨破培养基,影响菌落计数的结果。本试验利用新的培养基和新的涂布方法,对原方法进行改进,避免产气对计数结果的影响,提高菌落计数的准确性。
试验材料和方法
1
试验菌株和培养基
丁酸梭菌(由根源公司提供);GAM营养肉汤加15~20%的琼脂粉和0.05‰溴甲酚紫(指示剂);胰胨-亚硫酸盐-环丝氨酸琼脂基础(TSC)培养基;PBS缓冲溶液(0.8%NaCl,0.02%KH2PO4,0.115%Na2HPO4,调pH值为7.20)
2
样品的制备
样品的制备过程均应遵循无菌操作程序。
液体样品:液体样品应先将其充分摇匀后用无菌吸管吸取10 mL加入装有90 mLPBS缓冲溶液的250 mL的无菌三角瓶中(瓶内放置适当数量的玻璃珠),180 rpm,30 min振荡混匀,制成1:10的样品匀液。
粉末固体样品:称取1.0000 g固体样品,加入装有100 mLPBS缓冲溶液的250 mL的无菌三角瓶中(瓶内放置适当数量的玻璃珠),180 rpm,30 min振荡混匀,制成1:100的样品匀液。
3
试验操作步骤
1)用 1 mL 微量移液器吸头吸取 1:10 或1:100样品匀液 1 mL,沿管壁缓慢注于装有 9 mL PBS缓冲溶液的无菌试管中(注意尖端不要触及稀释液),将试管用涡旋混合器混合30 s,制成 1:100 或1:1000的样品匀液。
2)另取 1 mL 微量移液器吸头,按上述操作顺序,做 10 倍递增样品匀液,每递增稀释一次,即换用1次 1 mL 灭菌吸头。
3)选择 2 -3 个连续的适宜稀释度,试验操作参照下面“原计数方法和新计数方法的比较”。
4)可用肉眼观察,记录稀释倍数和相应的菌落数量。菌落计数以菌落形成单位(colony-forming units,CFU)表示。 选取菌落数在 30 CFU~300 CFU 之间、无蔓延菌落生长的平板计数菌落总数(称重取样以 CFU/g 为单位报告,体积取样以 CFU/mL 为单位报告)。
4
原计数方法和新计数方法的比较
原计数方法:选择2-3个连续的适宜稀释度,每个稀释度吸取1 mL 样品匀液与熔化好的保持在40~50℃左右的营养琼脂培养基充分混合,然后把这混合液倾注到无菌的培养皿中,待凝固之后,把这平板倒置在恒箱中培养24 h。
新计数方法:选择2-3个连续的适宜稀释度,每个稀释度吸取 0.1 mL 样品匀液分别置于TSC琼脂平板,使用 L 形棒进行表面涂布,待表层干燥后,继续倾注入上述培养基,待其全部凝固后,严格厌氧环境下37℃,培养24 h。
5
测定指标
菌落生长情况通过图片展示。
结果与分析
图1 原计数方法(左)和新计数方法(右)的比较
原计数方法和新计数方法的比较如图1所示:左边图片培养基被涨破,丁酸梭菌呈乳白色点状分布,右边图片培养基完整,丁酸梭菌呈圆形、黑色菌落。
讨论与结论
与原计数方法相比,新计数方法培养基完整,丁酸梭菌呈圆形、黑色菌落。

作者:王政
